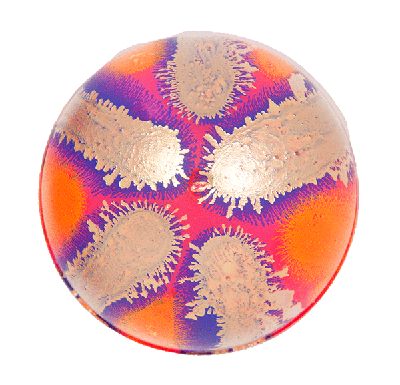
Plastic acorn or capsule covered in paint
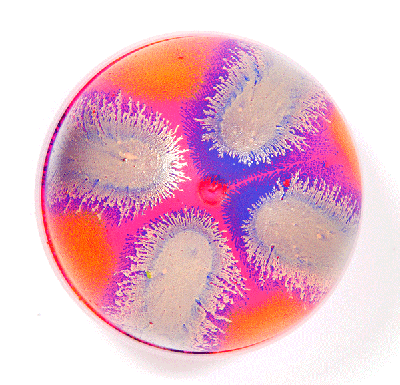
Plastic acorn or capsule covered in paint

ACORNS!
(AKA CAPSULES: PLASTIC CONTAINERS FOR !BOOKS!BOOKS!BOOKS!)














































































(AKA CAPSULES: PLASTIC CONTAINERS FOR !BOOKS!BOOKS!BOOKS!)